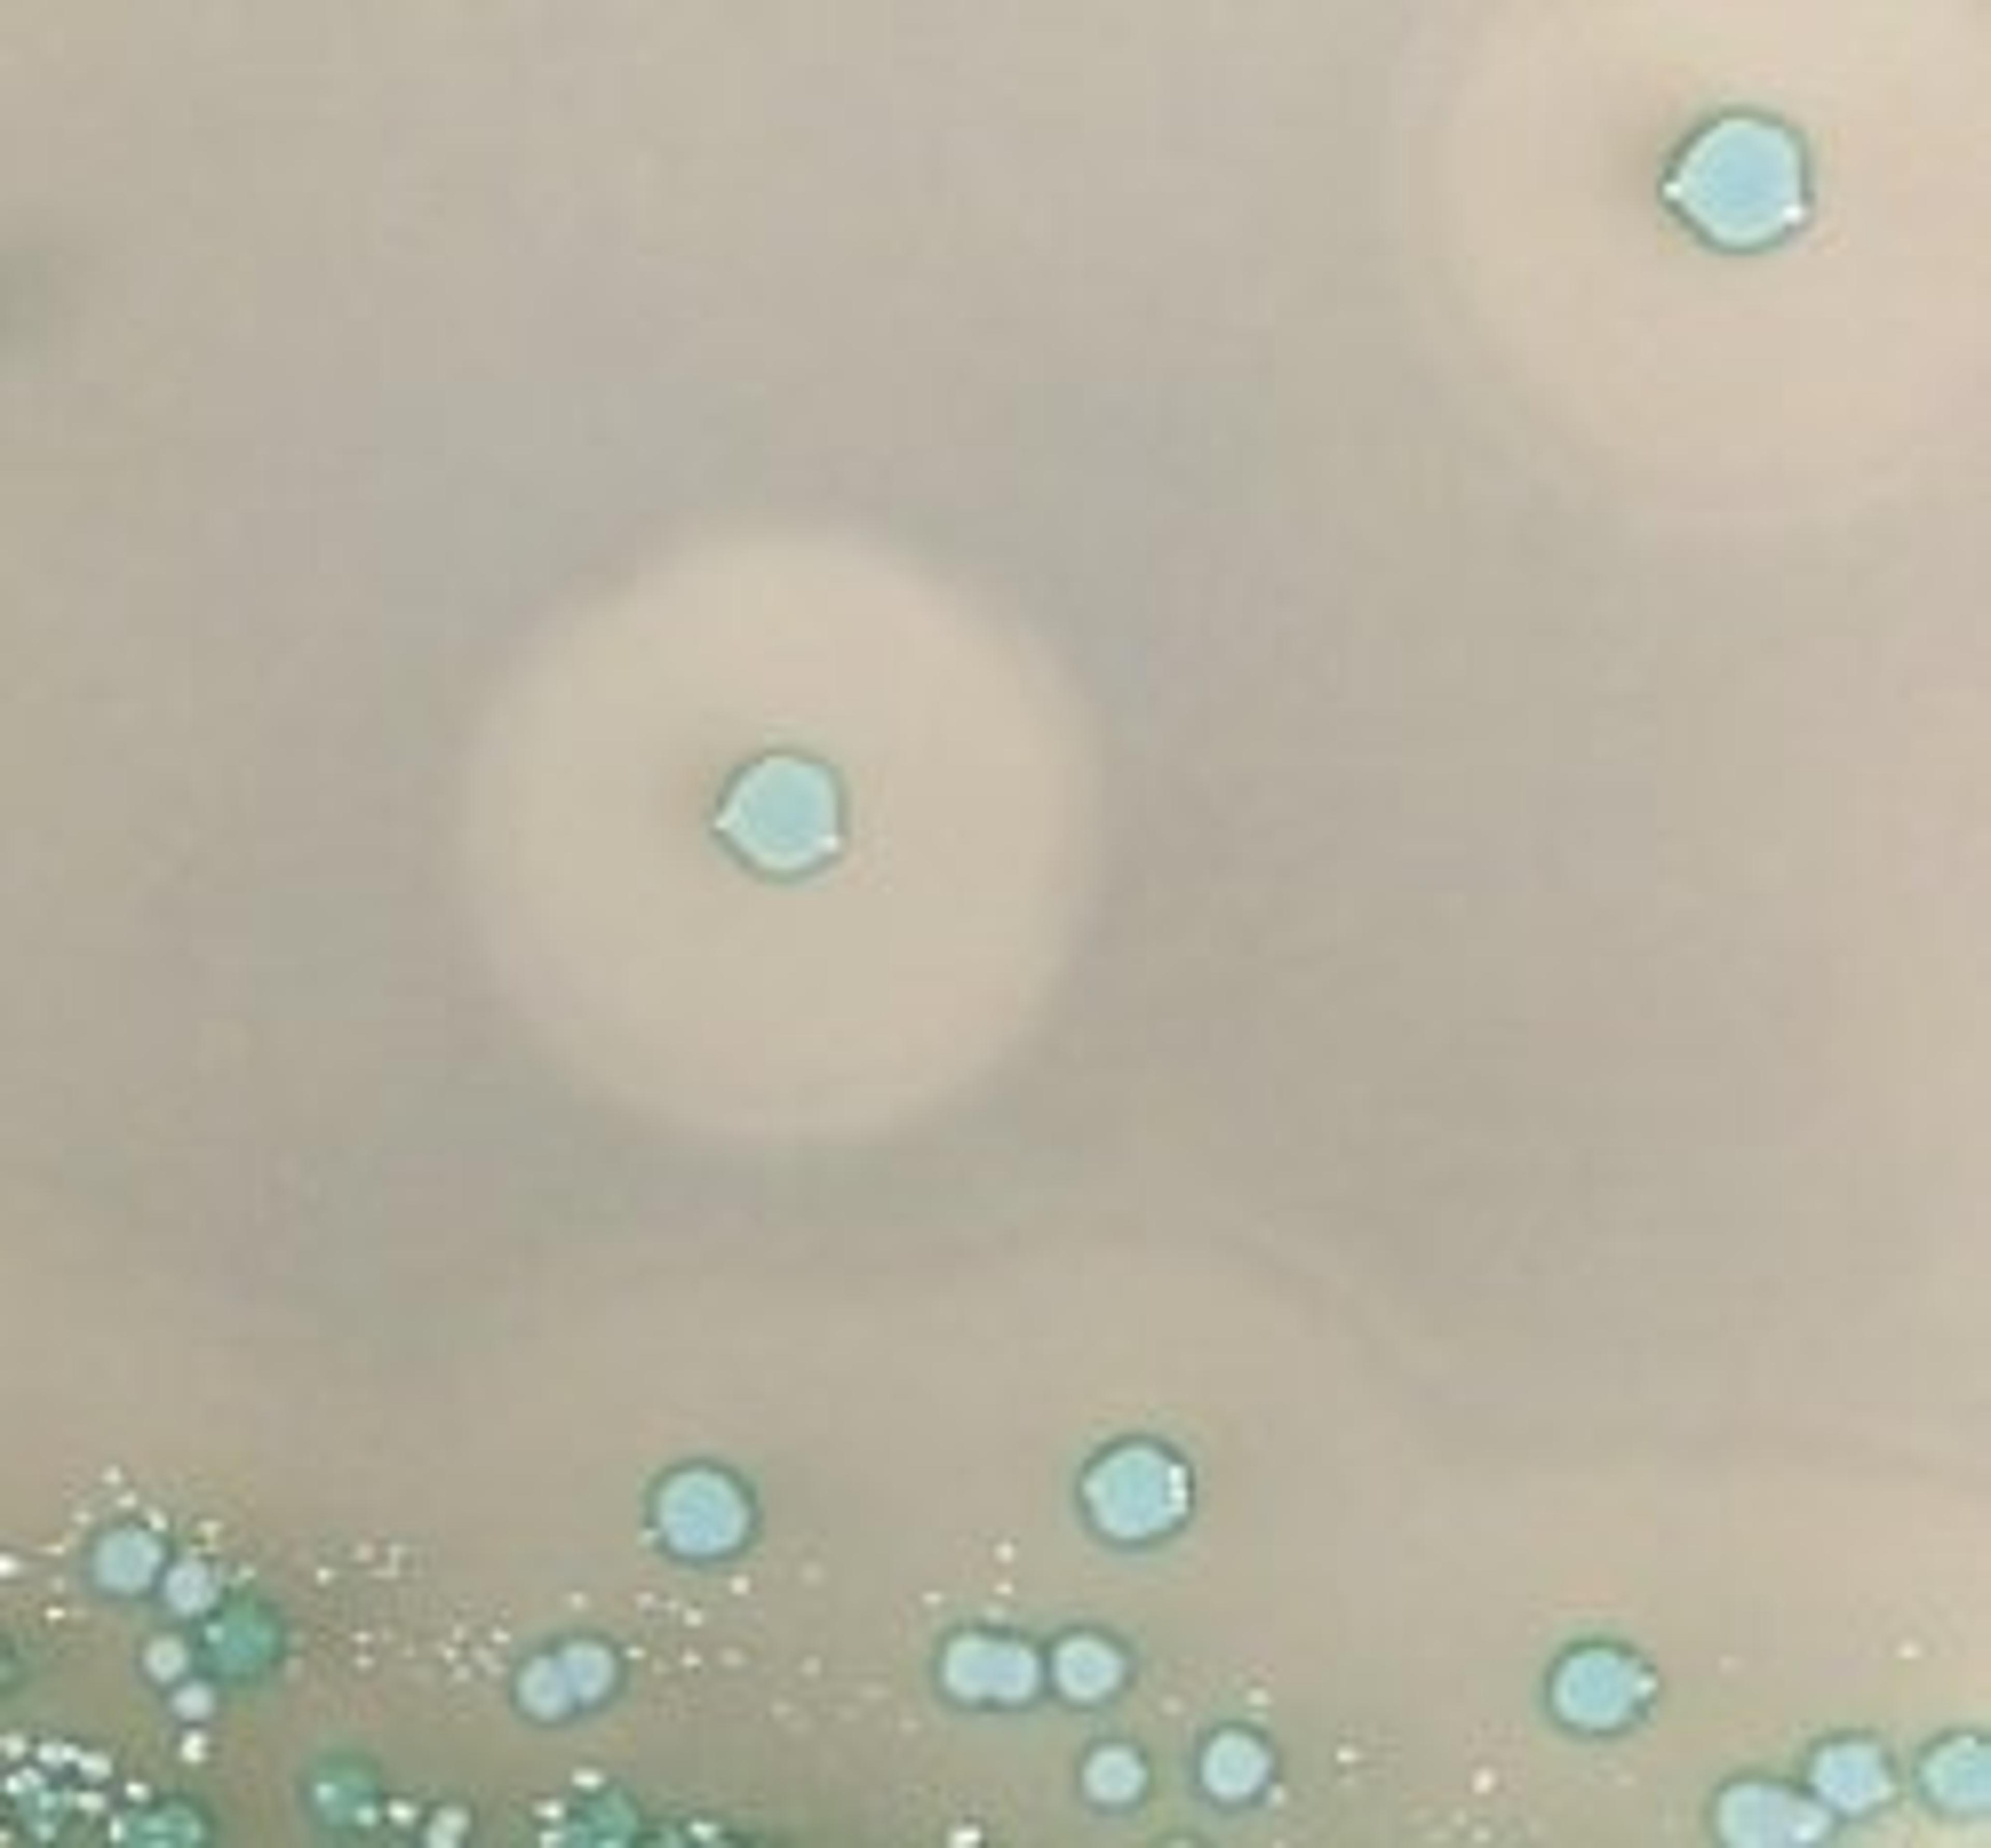

News & Articles
25
Selected Filters:
Product News
Ultra-High Throughput Microwave Reaction System
Product News
'Peter Huber Product of the month'
Product News
Tecan at AACC 2006
Product News
AbD Serotec at AACC 2006
Product News
AbD Serotec at AACC 2006
Product News